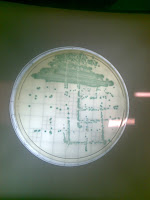

Το Ολλανδικό Εθνικό Ινστιτούτο για τη Δημόσια Υγεία και το Περιβάλλον σε έκθεσή-του ασχολείται με την καθιέρωση ορίων για το καμπυλοβακτηρίδιο σε πουλερικά. Το 2011 ενόσησαν 8490 άτομα στην Ολλανδία εκ των οποίων 34 κατέληξαν. Η μελέτη καταλήγει στα εξής ...
Listeria monocytogenes – Ανάκληση καπνιστού σολωμού στις ΗΠΑ!
Νέα ανάκληση καπνιστού σολωμού στις ΗΠΑ, εξαιτίας της παρουσίας Listeria monocytogenes, την τέταρτη κατά σειρά το τελευταίο δίμηνο. Πρόκειται για προϊόν Χιλής, της εταιρίας Productos Marinos Delifish, χωρίς να έχουν ευτυχώς υπάρξει νοσήσεις αυτή τη φορά. ...
(ΗΠΑ): Παρουσία του παθογόνου μικροοργανισμού E.coli 0157:H7 σε μίγμα με σπανάκι.
Η παρουσία του παθογόνου μικροοργανισμού E.coli 0157:H7 σε μίγμα σπανακιού και άλλων λαχανικών φέρεται να είναι η αιτία της ασθένειας 16 ατόμων μέχρι τώρα στη Νέα Υόρκη (ΗΠΑ). Η υπεύθυνη εταιρεία (Wegmans Food Markets) ανακοίνωσε την ανακληση όλων των πρ ...
(EFSA: Μείωση στα κρούσματα σαλμονέλωσης – Αύξηση στα κρούσματα καμπυλοβακτηρίωσης!
Σύμφωνα με την ετήσια έκθεση της Ευρωπαϊκής Αρχής για την Ασφάλεια των Τροφίμων (European Food Safety Authority, EFSA) και του Ευρωπαϊκού Κέντρου για την πρόληψη και αποτροπή διάδοσης ασθενειών, (European Centre for Disease Prevention and Control, ECDC), ...
Απαγορευμένα συντηρητικά (αντιβιοτικό) σε γιαούρτη στην Κύπρο!
Σύμφωνα με ανακοίνωση των αρμοδίων Αρχών στην Κύπρο, ανιχνεύθηκε σε γιαούρτια τριών διαφορετικών παρασκευαστών, το συντηρητικό ναταμυκίνη (Ε235), που δεν επιτρέπεται να υπάρχει σε γιαούρτι. Η ναταμυκίνη χρησιμοποιείται για να σταματά την ανάπτυξη των μυκή ...
“Απολυμαίνει σίγουρα; Γιατί ΔΕΝ ΤΟ ΓΡΑΦΕΙ!…”
Δηλαδή, τα διαλύματα απολυμαντικού χλωρίου είναι αποτελεσματικά γιατί "το γράφουν στην ετικέτα;", "γιατί έχουν άδεια (sic) από τους αρμόδιους;" ή "γιατί επιστημονικά έχει τεκμηριωθεί η αποτελεσματικότητά-τους;"Ακόμη ένα παράδειγμα ψευτο-ΣΔΙΤ ("Συμπράξεις ...
Διατροφικά σκάνδαλα στην Κίνα!
Δημοσιεύματα του Ελληνικού και ξένου τύπου αναφέρονται σε διαρκή διατροφικά σκάνδαλα στην Κίνα. Πρόσφατα, αφαιρέθηκε η άδεια από τους μισούς περίπου γαλακτοπαραγωγούς της χώρας. (Τρία παιδιά έχασαν τη ζωή τους από γάλα μολυσμένο με νιτρώδεις ενώσεις). Λίγ ...
Η ΑΝΑΓΚΑΙΟΤΗΤΑ ΤΟΥ ΕΝΙΑΙΟΥ ΦΟΡΕΑ ΕΛΕΓΧΟΥ ΤΡΟΦΙΜΩΝ (ΕΦΕΤ)!
Επειδή εξακολουθούν οι προφάσεις, οι ανακρίβειες, οι προτάσεις για "συντονισμένους συντονισμούς", κατά συνέπεια να συνεχίζεται ο αναποτελεσματικός έλεγχος τροφίμων, ποτών και υπηρεσιών (haccp)!Τί γράφαμε ακόμη και μέχρι το 2008:ΜΙΑ ΣΥΖΗΤΗΣΗ ΠΟΥ, ΔΥΣΤΥΧΩΣ, ...
Χωρίς πρόβλημα διοξινών το παστεριωμένο γάλα της Ρόδου:
Σύμφωνα με τα ευρήματα πρόσφατης εργαστηριακής δοκιμής, το παστεριωμένο - εμφιαλωμένο γάλα της Ρόδου δεν έχει πρόβλημα με διοξίνες.

.jpg)


